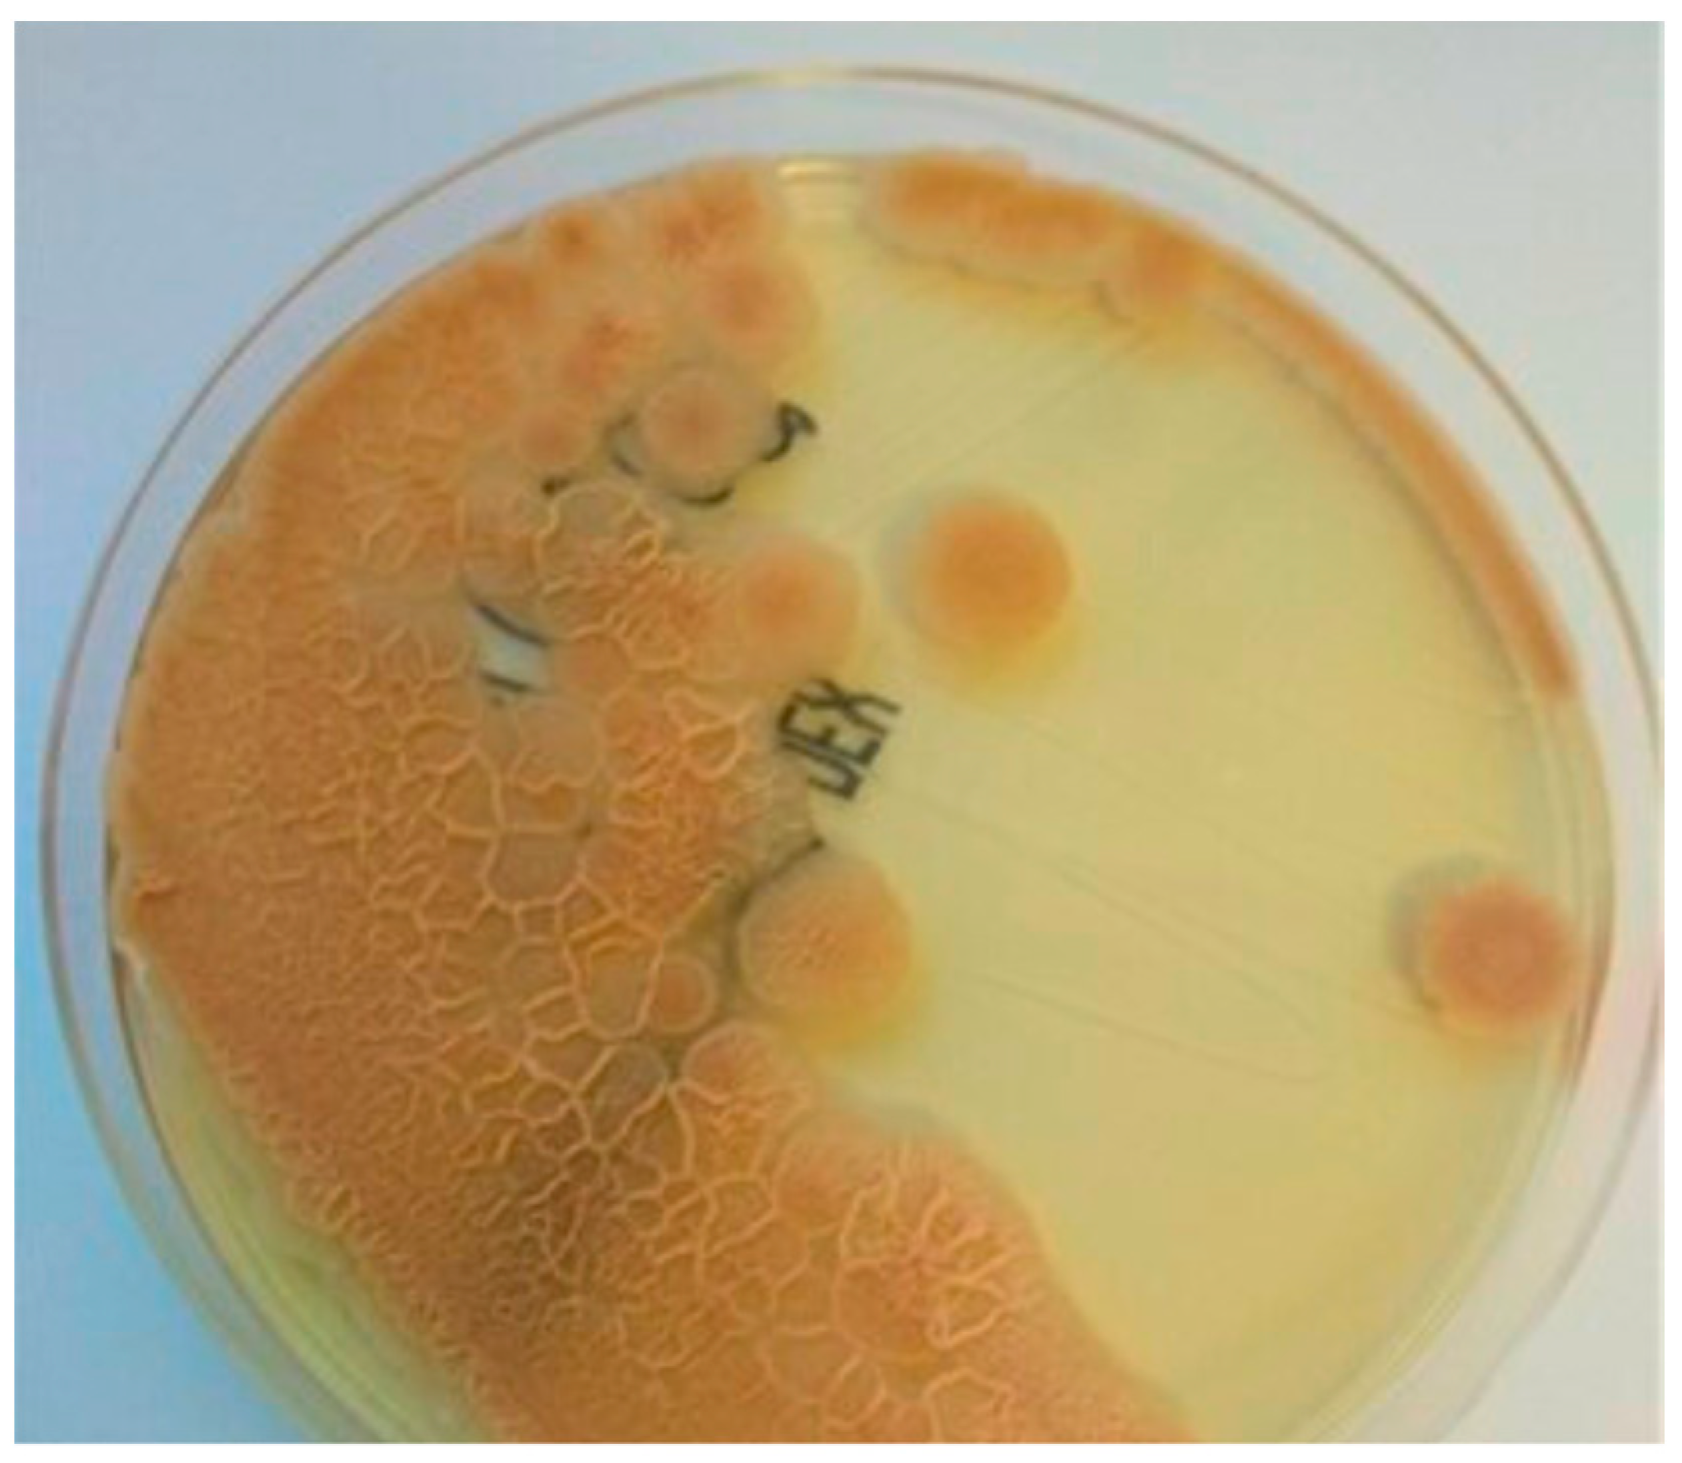
Jof 11 00095 g002

Moesziomyces aphidis Bloodstream Infection in Oncologic Patient: First Report in Poland
Abstract
1. Introduction
2. Case Report
2.1. Description of Patients
2.2. Mycological Investigation
3. Discussion
4. Conclusions
Author Contributions
Funding
Institutional Review Board Statement
Informed Consent Statement
Data Availability Statement
Conflicts of Interest
References
- Fang, W.; Wu, J.; Cheng, M.; Zhu, X.; Du, M.; Chen, C.; Liao, W.; Zhi, K.; Pan, W. Diagnosis of invasive fungal infections: Challenges and recent developments. J. Biomed. Sci. 2023, 30, 42. [Google Scholar] [CrossRef]
- von Lilienfeld-Toal, M.; Wagener, J.; Einsele, H.; Cornely, O.A.; Kurzai, O. Invasive Fungal Infection. Dtsch. Arztebl. Int. 2019, 116, 271–278. [Google Scholar] [CrossRef]
- Pappas, P.G.; Kauffman, C.A.; Andes, D.R.; Clancy, C.J.; Marr, K.A.; Ostrosky-Zeichner, L.; Reboli, A.C.; Schuster, M.G.; Vazquez, J.A.; Walsh, T.J.; et al. Clinical Practice Guideline for the Management of Candidiasis: 2016 Update by the Infectious Diseases Society of America. Clin. Infect. Dis. 2016, 62, e1–e50. [Google Scholar] [CrossRef] [PubMed]
- Tissot, F.; Agrawal, S.; Pagano, L.; Petrikkos, G.; Groll, A.H.; Skiada, A.; Lass-Florl, C.; Calandra, T.; Viscoli, C.; Herbrecht, R. ECIL-6 guidelines for the treatment of invasive candidiasis, aspergillosis and mucormycosis in leukemia and hematopoietic stem cell transplant patients. Haematologica 2017, 102, 433–444. [Google Scholar] [CrossRef] [PubMed]
- Mora Carpio, A.L.; Climaco, A. Candidemia. In StatPearls; StatPearls Publishing: Treasure Island, FL, USA, 2024. [Google Scholar]
- Long, B.; Lacy, A.J.; Koyfman, A.; Liang, S.Y. Candida auris: A focused review for emergency clinicians. Am. J. Emerg. Med. 2024, 84, 162–167. [Google Scholar] [CrossRef] [PubMed]
- Casalini, G.; Giacomelli, A.; Antinori, S. The WHO fungal priority pathogens list: A crucial reappraisal to review the prioritisation. Lancet Microbe 2024, 5, 717–724. [Google Scholar] [CrossRef] [PubMed]
- Sugita, T.; Takashima, M.; Poonwan, N.; Mekha, N.; Malaithao, K.; Thungmuthasawat, B.; Prasarn, S.; Luangsook, P.; Kudo, T. The first isolation of ustilaginomycetous anamorphic yeasts, Pseudozyma species, from patients’ blood and a description of two new species: P. parantarctica and P. thailandica. Microbiol. Immunol. 2003, 47, 183–190. [Google Scholar] [CrossRef]
- Herb, A.; Sabou, M.; Delhorme, J.B.; Pessaux, P.; Mutter, D.; Candolfi, E.; Letscher-Bru, V. Pseudozyma aphidis fungemia after abdominal surgery: First adult case. Med. Mycol. Case Rep. 2015, 8, 37–39. [Google Scholar] [CrossRef]
- Liu, Y.; Zou, Z.; Hu, Z.; Wang, W.; Xiong, J. Morphology and Molecular Analysis of Moesziomyces antarcticus Isolated from the Blood Samples of a Chinese Patient. Front. Microbiol. 2019, 10, 254. [Google Scholar] [CrossRef]
- Maccaro, A.; Pascale, R.; Liberatore, A.; Turello, G.; Ambretti, S.; Viale, P.; Cricca, M. Pseudozyma aphidis bloodstream infection in a patient with aggressive lymphoma and a history of intravenous drug use: Case report and review of the literature. Med. Mycol. Case Rep. 2021, 33, 5–8. [Google Scholar] [CrossRef]
- Mpakosi, A.; Siopi, M.; Demetriou, M.; Falaina, V.; Theodoraki, M.; Meletiadis, J. Fungemia due to Moesziomyces aphidis (Pseudozyma aphidis) in a premature neonate. Challenges in species identification and antifungal susceptibility testing of rare yeasts. J. Mycol. Med. 2022, 32, 101258. [Google Scholar] [CrossRef] [PubMed]
- The European Committee on Antimicrobial Susceptibility Testing. Overview of Antifungal ECOFFs and Clinical Breakpoints for Yeasts, Moulds and Dermatophytes Using the EUCAST E.Def 7.3, E.Def 9.4 and E.Def 11.0 Procedures. Version 3, 2022; The European Committee on Antimicrobial Susceptibility Testing: Växjö, Sweden, 2022; Available online: http://www.eucast.org (accessed on 7 January 2025).
- The European Committee on Antimicrobial Susceptibility Testing. Overview of antifungal ECOFFs and Clinical Breakpoints for Yeasts, Moulds and Dermatophytes Using the EUCAST E.Def 7.4, E.Def 9.4 and E.Def 11.0 Procedures. Version 4.0, 2023; The European Committee on Antimicrobial Susceptibility Testing: Växjö, Sweden, 2023; Available online: http://www.eucast.org (accessed on 7 January 2025).
- The European Committee on Antimicrobial Susceptibility Testing. Breakpoint Tables for Interpretation of MICs for Antifungal Agents, Version 11.0, 2024; The European Committee on Antimicrobial Susceptibility Testing: Växjö, Sweden, 2024; Available online: http://www.eucast.org/astoffungi/clinicalbreakpointsforantifungals/ (accessed on 7 January 2025).
- The European Committee on Antimicrobial Susceptibility Testing. The European Committee on Antimicrobial Susceptibility Testing. Overview of Antifungal ECOFFs and Clinical Breakpoints for Yeasts, Moulds and Dermatophytes Using the EUCAST E.Def 7.4, E.Def 9.4 and E.Def 11.0 Procedures. Version 5.0, 2024; The European Committee on Antimicrobial Susceptibility Testing: Växjö, Sweden, 2024; Available online: http://www.eucast.org (accessed on 7 January 2025).
- EUCAST Guidance on Interpretation of MICs for Rare Yeast Without Breakpoints in Breakpoint Tables 2024-06-19 EUCAST; European Committee on Antimicrobial Susceptibility Testing: Växjö, Sweden, 2024.
- Kimura, M.; Asano-Mori, Y.; Sakoh, T.; Abe, M.; Ueno, K.; Hoshino, Y.; Nakamura, S.; Umeyama, T.; Yamagoe, S.; Miyazaki, Y.; et al. Factors Associated with Breakthrough Fungemia Caused by Candida, Trichosporon, or Fusarium Species in Patients with Hematological Disorders. Antimicrob. Agents Chemother. 2022, 66, e0208121. [Google Scholar] [CrossRef] [PubMed]
- Berkow, E.L.; Lockhart, S.R.; Ostrosky-Zeichner, L. Antifungal Susceptibility Testing: Current Approaches. Clin. Microbiol. Rev. 2020, 33, 10–1128. [Google Scholar] [CrossRef]
- Kruse, J.; Doehlemann, G.; Kemen, E.; Thines, M. Asexual and sexual morphs of Moesziomyces revisited. IMA Fungus 2017, 8, 117–129. [Google Scholar] [CrossRef] [PubMed]
- Telles, J.P.; Ribeiro, V.S.T.; Kraft, L.; Tuon, F.F. Pseudozyma spp. human infections: A systematic review. Med. Mycol. 2021, 59, 1–6. [Google Scholar] [CrossRef]
- Joo, H.; Choi, Y.G.; Cho, S.Y.; Choi, J.K.; Lee, D.G.; Kim, H.J.; Jo, I.; Park, Y.J.; Lee, K.Y. Pseudozyma aphidis fungaemia with invasive fungal pneumonia in a patient with acute myeloid leukaemia: Case report and literature review. Mycoses 2016, 59, 56–61. [Google Scholar] [CrossRef]
- Lin, S.S.; Pranikoff, T.; Smith, S.F.; Brandt, M.E.; Gilbert, K.; Palavecino, E.L.; Shetty, A.K. Central venous catheter infection associated with Pseudozyma aphidis in a child with short gut syndrome. J. Med. Microbiol. 2008, 57, 516–518. [Google Scholar] [CrossRef]
- Prakash, A.; Wankhede, S.; Singh, P.K.; Agarwal, K.; Kathuria, S.; Sengupta, S.; Barman, P.; Meis, J.F.; Chowdhary, A. First neonatal case of fungaemia due to Pseudozyma aphidis and a global literature review. Mycoses 2014, 57, 64–68. [Google Scholar] [CrossRef]
- Orecchini, L.A.; Olmos, E.; Taverna, C.G.; Murisengo, O.A.; Szuzs, W.; Vivot, W.; Córdoba, S.; Bosco-Borgeat, M.E.; Montanaro, P.C. First Case of Fungemia Due to Pseudozyma aphidis in a Pediatric Patient with Osteosarcoma in Latin America. J. Clin. Microbiol. 2015, 53, 3691–3694. [Google Scholar] [CrossRef]
- Parahym, A.M.; da Silva, C.M.; Domingos Ide, F.; Gonçalves, S.S.; Rodrigues Mde, M.; de Morais, V.L.; Neves, R.P. Pulmonary infection due to Pseudozyma aphidis in a patient with Burkitt lymphoma: First case report. Diagn. Microbiol. Infect. Dis. 2013, 75, 104–106. [Google Scholar] [CrossRef]
- Voon, S.M.; Upton, A.; Gupta, D. Pseudozyma aphidis endophthalmitis post-cataract operation: Case discussion and management. Am. J. Ophthalmol. Case Rep. 2019, 15, 100475. [Google Scholar] [CrossRef] [PubMed]
- Chen, B.; Zhu, L.Y.; Xuan, X.; Wu, L.J.; Zhou, T.L.; Zhang, X.Q.; Li, B.X. Isolation of both Pseudozyma aphidis and Nocardia otitidiscaviarum from a mycetoma on the leg. Int. J. Dermatol. 2011, 50, 714–719. [Google Scholar] [CrossRef] [PubMed]
- Pande, A.; Non, L.R.; Romee, R.; Santos, C.A.Q. Pseudozyma and other non-Candida opportunistic yeast bloodstream infections in a large stem cell transplant center. Transpl. Infect. Dis. 2017, 19, e12664. [Google Scholar] [CrossRef]
- Siddiqui, W.; Ahmed, Y.; Albrecht, H.; Weissman, S. Pseudozyma spp catheter-associated blood stream infection, an emerging pathogen and brief literature review. BMJ Case Rep. 2014, 2014, bcr2014206369. [Google Scholar] [CrossRef]
- Kohli, U.; Hazra, A.; Shahab, A.; Beaser, A.D.; Aziz, Z.A.; Upadhyay, G.A.; Ozcan, C.; Tung, R.; Nayak, H.M. Atypical pathogens associated with cardiac implantable electronic device infections. Pacing Clin. Electrophysiol. 2021, 44, 1549–1561. [Google Scholar] [CrossRef] [PubMed]
- Hu, F.; Wang, C.; Wang, P.; Zhang, L.; Jiang, Q.; Al-Hatmi, A.M.S.; Blechert, O.; Zhan, P. First Case of Subcutaneous Mycoses Caused by Dirkmeia churashimaensis and a Literature Review of Human Ustilaginales Infections. Front. Cell Infect. Microbiol. 2021, 11, 711768. [Google Scholar] [CrossRef]
- Hwang, S.; Kim, J.; Yoon, S.; Cha, Y.; Kim, M.; Yong, D.; Chang, J.H.; Jeong, S.H.; Uh, Y.; Lee, K. First report of brain abscess associated with Pseudozyma species in a patient with astrocytoma. Korean J. Lab. Med. 2010, 30, 284–288. [Google Scholar] [CrossRef] [PubMed]
- Gil, E.; Durán, M.T.; Rodríguez-Tudela, J.L.; Cuenca-Estrella, M.; Cartelle, M.; Molina, F.; Guerrero, A. Pseudozyma sp.: Colonizer of the respiratory tract in critical patients. Enferm. Infecc. Microbiol. Clin. 2003, 21, 65. [Google Scholar] [CrossRef]
- Lin, S.Y.; Lu, P.L.; Tan, B.H.; Chakrabarti, A.; Wu, U.I.; Yang, J.H.; Patel, A.K.; Li, R.Y.; Watcharananan, S.P.; Liu, Z.; et al. The epidemiology of non-Candida yeast isolated from blood: The Asia Surveillance Study. Mycoses 2019, 62, 112–120. [Google Scholar] [CrossRef]
- Narayanan, S.; Chua, J.V.; Baddley, J.W. Coronavirus Disease 2019-Associated Mucormycosis: Risk Factors and Mechanisms of Disease. Clin. Infect. Dis. 2022, 74, 1279–1283. [Google Scholar] [CrossRef]
- Corrêa-Junior, D.; Andrade, I.B.; Alves, V.; Araújo, G.R.S.; Frases, S. Clinical Challenges of Emerging and Re-Emerging Yeast Infections in the Context of the COVID-19 Pandemic. Microorganisms 2022, 10, 2223. [Google Scholar] [CrossRef] [PubMed]
- Naveen, K.V.; Saravanakumar, K.; Sathiyaseelan, A.; MubarakAli, D.; Wang, M.H. Human Fungal Infection, Immune Response, and Clinical Challenge-a Perspective During COVID-19 Pandemic. Appl. Biochem. Biotechnol. 2022, 194, 4244–4257. [Google Scholar] [CrossRef] [PubMed]
- Koulenti, D.; Paramythiotou, E.; Almyroudi, M.P.; Karvouniaris, M.; Markou, N.; Paranos, P.; Routsi, C.; Meletiadis, J.; Blot, S. Severe mold fungal infections in critically ill patients with COVID-19. Future Microbiol. 2024, 19, 825–840. [Google Scholar] [CrossRef] [PubMed]
- Pourazizi, M.; Hakamifard, A.; Peyman, A.; Mohammadi, R.; Dehghani, S.; Tavousi, N.; Hosseini, N.S.; Azhdari Tehrani, H.; Abtahi-Naeini, B. COVID-19 associated mucormycosis surge: A review on multi-pathway mechanisms. Parasite Immunol. 2024, 46, e13016. [Google Scholar] [CrossRef]
- Farooq, H.; Sabesan, G.S.; Monowar, T.; Chinni, S.V.; Zainol, N.H. Case report of a rare fungal infection Kodamaea ohmeri in COVID-19 patient in North Malaysian hospital. Indian. J. Pathol. Microbiol. 2024, 67, 654–657. [Google Scholar] [CrossRef] [PubMed]
- Gade, N.; Nag, S.; Prathipati, K.K.; Mishra, M.; Shete, V. Chaetomium globosum: Spotting a scarce saprophyte in bacterial-fungal co-infection of the sinuses in a post-COVID-19 patient. Med. Mycol. Case Rep. 2024, 43, 100618. [Google Scholar] [CrossRef]
- Giusiano, G.; Tracogna, F.; Messina, F.; Sosa, V.; Rojas, F.; Chacón, Y.; Vásquez, A.; de Los Ángeles Sosa, M.; Formosa, P.; Fernández, M.; et al. Impact of COVID-19 on paracoccidioidomycosis. Which was the most influential: The pandemic or the virus? Mycoses 2024, 67, e13761. [Google Scholar] [CrossRef]
- Iturrieta-González, I.; Giacaman, A.; Godoy-Martínez, P.; Vega, F.; Sepúlveda, M.; Santos, C.; Toledo, V.; Rivera, G.; Ortega, L.; San Martín, A.; et al. Penicillium digitatum, First Clinical Report in Chile: Fungal Co-Infection in COVID-19 Patient. J. Fungi 2022, 8, 961. [Google Scholar] [CrossRef]
- Benelli, J.L.; Basso, R.P.; Grafulha, T.W.; Poester, V.R.; Munhoz, L.S.; Martins, K.B.; Zogbi, H.E.; Von Groll, A.; Severo, C.B.; Stevens, D.A.; et al. Fungal Bloodstream Co-infection by Trichosporon asahii in a COVID-19 Critical Patient: Case Report and Literature Review. Mycopathologia 2022, 187, 397–404. [Google Scholar] [CrossRef]
- Arendrup, M.C.; Boekhout, T.; Akova, M.; Meis, J.F.; Cornely, O.A.; Lortholary, O. ESCMID and ECMM joint clinical guidelines for the diagnosis and management of rare invasive yeast infections. Clin. Microbiol. Infect. 2014, 20 (Suppl. S3), 76–98. [Google Scholar] [CrossRef]
- Chen, S.C.; Perfect, J.; Colombo, A.L.; Cornely, O.A.; Groll, A.H.; Seidel, D.; Albus, K.; de Almedia, J.N., Jr.; Garcia-Effron, G.; Gilroy, N.; et al. Global guideline for the diagnosis and management of rare yeast infections: An initiative of the ECMM in cooperation with ISHAM and ASM. Lancet Infect. Dis. 2021, 21, e375–e386. [Google Scholar] [CrossRef] [PubMed]
- Cornely, O.A.; Cuenca-Estrella, M.; Meis, J.F.; Ullmann, A.J. European Society of Clinical Microbiology and Infectious Diseases (ESCMID) Fungal Infection Study Group (EFISG) and European Confederation of Medical Mycology (ECMM) 2013 joint guidelines on diagnosis and management of rare and emerging fungal diseases. Clin. Microbiol. Infect. 2014, 20 (Suppl. S3), 1–4. [Google Scholar] [CrossRef] [PubMed]
- Cuenca-Estrella, M.; Verweij, P.E.; Arendrup, M.C.; Arikan-Akdagli, S.; Bille, J.; Donnelly, J.P.; Jensen, H.E.; Lass-Florl, C.; Richardson, M.D.; Akova, M.; et al. ESCMID* guideline for the diagnosis and management of Candida diseases 2012: Diagnostic procedures. Clin. Microbiol. Infect. 2012, 18 (Suppl. S7), 9–18. [Google Scholar] [CrossRef]
- Robert, M.G.; Cornet, M.; Hennebique, A.; Rasamoelina, T.; Caspar, Y.; Pondérand, L.; Bidart, M.; Durand, H.; Jacquet, M.; Garnaud, C.; et al. MALDI-TOF MS in a Medical Mycology Laboratory: On Stage and Backstage. Microorganisms 2021, 9, 1283. [Google Scholar] [CrossRef]
- Álvarez-Rodríguez, J.C.; Blanco-Bustos, M.P.; Cuervo-Maldonado, S.I.; Gómez-Rincón, J.C.; Reyes, Á. Geotrichosis: Fungemia in a patient with acute lymphoblastic leukemia. Biomedica 2023, 43, 32–40. [Google Scholar] [CrossRef] [PubMed]
- Mawad, T.N.; Alfaifi, R.A.; Almazyed, O.M.; Alhumaidi, R.A.; Alsubaie, A.M. Fungemia Due to Saprochaete capitata in a Non-Neutropenic Critically Ill Patient. Cureus 2023, 15, e51147. [Google Scholar] [CrossRef]
- Ioannou, P.; Baliou, S.; Kofteridis, D.P. Fungemia by Wickerhamomyces anomalus-A Narrative Review. Pathogens 2024, 13, 269. [Google Scholar] [CrossRef] [PubMed]
- Zhu, H.-H.; Liu, M.-M.; Boekhout, T.; Wang, Q.-M. Improvement of a MALDI-TOF database for the reliable identification of Candidozyma auris (formally Candida auris) and related species. Microbiol. Spectr. 2024, 13, e01444-24. [Google Scholar] [CrossRef]
- de Luna, F.F.Á. Chapter Fourteen—Use of MALDI-TOF Mass Spectrometry in Fungal Diagnosis. In The Use of Mass Spectrometry Technology (MALDI-TOF) in Clinical Microbiology; Cobo, F., Ed.; Academic Press: New York, NY, USA, 2018; pp. 197–211. [Google Scholar]
- Montravers, P.; Mira, J.P.; Gangneux, J.P.; Leroy, O.; Lortholary, O.; AmarCand Study Group. A multicentre study of antifungal strategies and outcome of Candida spp. peritonitis in intensive-care units. Clin. Microbiol. Infect. 2011, 17, 1061–1067. [Google Scholar] [CrossRef]
- Sulik-Tyszka, B.; Wróblewska, M. A review of laboratory methods for diagnosis of invasive fungal infections. J. Lab. Diagn. 2015, 51, 147–152. [Google Scholar] [CrossRef]
- Sulik-Tyszka, B.; Cieślik, J.; Niewiński, G.; Wróblewska, M. Epidemiological analysis and evaluation of in vitro susceptibility to micafungin of clinical strains of Candida spp. causing fungaemia in patients hospitalised in intensive care unit. Forum Zakażeń 2017, 8, 157–161. [Google Scholar] [CrossRef]

| Antifungal Agent | MIC Range Value (µg/mL) of Our Isolate | Range of the MIC Value (µg/mL) from European Cases |
|---|---|---|
| amphotericin B | 0.125 a,b | 0.19 c; 0.5 d; 0.25 e |
| voriconazole | 0.125 a,b | 0.032 c; 0.031 d; 0.015/0.006 e |
| itraconazole | ND | 0.19 c; 0.5 d; 0.03/0.06 e |
| fluconazole | >256 a,b | 16 c; 4 d; 2/4 e |
| isavuconazole | ND | ND c,d,e |
| posaconazole | ND | 0.094 c; 0.031 d; 0.03/0.125 e |
| flucytosine | ND | >32 c; ND d; >64 e |
| caspofungin | >8 a; >32 b | >32 c; >8 d; >8 e |
| anidulafungin | >8 a; >32 b | ND c; >8 d; >8 e |
| micafungin | >8 a; >32 b | ND c; >8 d; >8 e |
Disclaimer/Publisher’s Note: The statements, opinions and data contained in all publications are solely those of the individual author(s) and contributor(s) and not of MDPI and/or the editor(s). MDPI and/or the editor(s) disclaim responsibility for any injury to people or property resulting from any ideas, methods, instructions or products referred to in the content. |
© 2025 by the authors. Licensee MDPI, Basel, Switzerland. This article is an open access article distributed under the terms and conditions of the Creative Commons Attribution (CC BY) license (https://creativecommons.org/licenses/by/4.0/).
Share and Cite
Sulik-Tyszka, B.; Małyszko, J.; Pęczuła, A.; Jarzynka, S. Moesziomyces aphidis Bloodstream Infection in Oncologic Patient: First Report in Poland. J. Fungi 2025, 11, 95. https://doi.org/10.3390/jof11020095
Sulik-Tyszka B, Małyszko J, Pęczuła A, Jarzynka S. Moesziomyces aphidis Bloodstream Infection in Oncologic Patient: First Report in Poland. Journal of Fungi. 2025; 11(2):95. https://doi.org/10.3390/jof11020095
Chicago/Turabian StyleSulik-Tyszka, Beata, Jolanta Małyszko, Agnieszka Pęczuła, and Sylwia Jarzynka. 2025. "Moesziomyces aphidis Bloodstream Infection in Oncologic Patient: First Report in Poland" Journal of Fungi 11, no. 2: 95. https://doi.org/10.3390/jof11020095
APA StyleSulik-Tyszka, B., Małyszko, J., Pęczuła, A., & Jarzynka, S. (2025). Moesziomyces aphidis Bloodstream Infection in Oncologic Patient: First Report in Poland. Journal of Fungi, 11(2), 95. https://doi.org/10.3390/jof11020095

